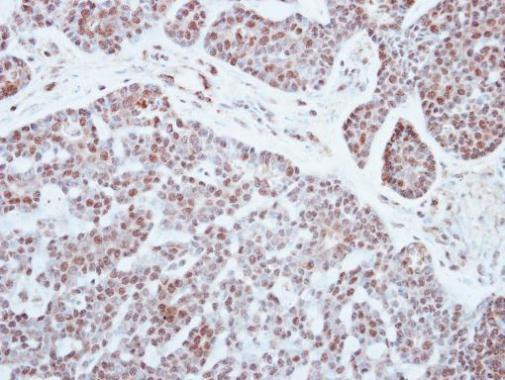
PATZ1 Antibody in Immunohistochemistry (Paraffin) (IHC (P))

Search
Invitrogen
PATZ1 Polyclonal Antibody
{{$productOrderCtrl.translations['antibody.pdp.commerceCard.promotion.promotions']}}
{{$productOrderCtrl.translations['antibody.pdp.commerceCard.promotion.viewpromo']}}
{{$productOrderCtrl.translations['antibody.pdp.commerceCard.promotion.promocode']}}: {{promo.promoCode}} {{promo.promoTitle}} {{promo.promoDescription}}. {{$productOrderCtrl.translations['antibody.pdp.commerceCard.promotion.learnmore']}}
产品信息
PA5-30478
宿主/亚型
分类
类型
抗原
偶联物
形式
浓度
规格
保存条件
运输条件
RRID
产品详细信息
Recommended positive controls: A549, HeLa, HepG2, HCT116.
Predicted reactivity: Mouse (99%), Rat (99%), Rabbit (99%), Bovine (99%).
Store product as a concentrated solution. Centrifuge briefly prior to opening the vial.
靶标信息
The protein encoded by this gene contains an A-T hook DNA binding motif which usually binds to other DNA binding structures to play an important role in chromatin modeling and transcription regulation. Its Poz domain is thought to function as a site for protein-protein interaction and is required for transcriptional repression, and the zinc-fingers comprise the DNA binding domain. Since the encoded protein has typical features of a transcription factor, it is postulated to be a repressor of gene expression. In small round cell sarcoma, this gene is fused to EWS by a small inversion of 22q, then the hybrid is thought to be translocated (t(1;22)(p36. 1;q12). The rearrangement of chromosome 22 involves intron 8 of EWS and exon 1 of this gene creating a chimeric sequence containing the transactivation domain of EWS fused to zinc finger domain of this protein. This is a distinct example of an intra-chromosomal rearrangement of chromosome 22. Four alternatively spliced transcript variants are described for this gene.
⚠WARNING: This product can expose you to chemicals including mercury, which is known to the State of California to cause birth defects or other reproductive harm. For more information go to www.P65Warnings.ca.gov.
仅用于科研。不用于诊断过程。未经明确授权不得转售。